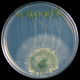
Los grandes beneficios de los Trichodermas como bioestimulante

Los grandes beneficios de los Trichodermas como bioestimulante
En los últimos 15 años, el destacado investigador mexicano ha estudiado los distintos lenguajes de comunicación entre microorganismos (trichodermas- bacterias) y plantas. “Los trichodermas ayudan a la planta a crecer, aportan fósforo y ayudan a las plantas frente a estrés biótico y abiótico”, señala.
José López Bucio será uno de los conferencistas invitados en el Congreso Biostimulantes Latam que organizará Redagrícola el 9, 10 y 11 de junio. www.bioestimulanteslatam.com.
Banyeliz Muñoz
Las plantas son seres vivos y tienen una relación muy estrecha con ciertos microorganismos que se encuentran en el suelo. Forman una simbiosis: una interacción mutua en que ambos se benefician. Este vínculo que tienen las especies vegetales con algunos organismos –hongos y bacterias- es la principal línea de investigación del doctor José López Bucio, profesor e investigador titular del Instituto de Investigaciones Químico Biológicas de la Universidad Michoacana de San Nicolás de Hidalgo (UMSNH) y miembro nivel III del Sistema Nacional de Investigadores (SNI), de México.
Su doctorado lo realizó en biología molecular de las plantas, abordando temáticas relacionadas con el desarrollo de especies transgénicas, análisis molecular, y transformación genética de las plantas. Culminó sus estudios en 2001, y en aquella ocasión tuvo la oportunidad de conocer al doctor Alfredo Herrera Estrella –especialista en el análisis de genómica funcional de plantas y hongos, y experto mundial en trichodermas-, quien le enseñó aspectos claves sobre estas cepas, despertando el interés de López Bucio en profundizar respecto a ellas. De hecho, hoy lleva 15 años trabajando de lleno en este tipo de vínculos entre plantas y microorganismos.

CONTROLADORES BIOLÓGICOS: SE ALIMENTAN DE CONTENIDOS CELULARES DE PATÓGENOS
El género trichodermas fue descubierto el siglo XVIII. Según algunos informes académicos, fue descrito por el micólogo sudafricano Christiaan Hendrik Persoon en 1794. Y su acción como micoparásito natural se demostró por Weindling en 1932. Sin embargo, su utilización en experimentos de control biológico se implementó a partir de 1970. Desde esa fecha su principal uso en la agricultura es para esos fines (más detalles aquí).
“Las plantas son fotosintéticas y fabrican su alimento. Con que exista luz solar, nutrientes, agua y minerales en el suelo pueden crecer sin ningún problema. Por otro lado, existen diferentes microorganismos: bacterias y hongos que están de manera natural en todos los ecosistemas, ya sea desierto, selva, pastizales. Los trichodermas se alimentan de otros hongos. O sea, son micoparásitos. Y ello lo hace una excelente herramienta para la agricultura. Si uno aplica trichodermas a las raíces de los cultivos, estas cepas van alimentarse de aquellos hongos que están proliferando en esa región cerca de la planta. No tienes que aplicar pesticidas o fungicidas: tienes una herramienta de control biológico”, resume.

Destaca que grupos de investigación -como los de Herrera Estrella- han profundizado bastante respecto a este proceso. “Los trichodermas son antagonistas de patógenos de plantas. Liberan unas enzimas, unas pequeñas proteínas, que hacen hoyos en las estructuras de otros hongos, y se alimentan de sus contenidos celulares. Su grupo de análisis indagó sobre cómo lo hacía el trichoderma para secretar esas enzimas, cuando hay otros hongos, a los cuales les llaman presas. Estudiaron sobre cómo hacía este hongo para reconocer a sus presas. Empezaron a encontrar muchas características”, cuenta.
SU ROL COMO BIOESTIMULANTES DE PLANTAS: MEJORA EL VIGOR DEL CULTIVO
Análisis como estos llevaron a profundizar sobre otras materias en relación a este tipo de cepas. Por ejemplo, si existía alguna relación benéfica de la planta con algunos de estos microorganismos. El grupo de investigación de López Bucio abordó sus estudios basándose en dos cepas de Trichodermas: T. virens, y T.atro-viride. Además del trabajo con estos hongos, también lo ha hecho con 5000 bacterias. De sus diversos análisis se desprende que algunas especies pueden funcionar como bioestimulantes para las plantas. Lo que va en línea con las prácticas sustentables que se buscan hoy en la producción agrícola.
-¿Cuántas especies existen? ¿Dónde se encuentran?
-A la fecha, se han detectado unas 200. Son cosmopolitas: viven en todo el mundo y en todos los ambientes. Están prácticamente en todos lados. Hay hasta especies marinas. Se ubican en materia orgánica en descomposición (por ejemplo, tallos pudriéndose). A los hongos les gustan los lugares donde hay comida, que es la materia orgánica.

-¿Por qué no atacan a las plantas?
-Es una pregunta muy interesante que se está estudiando ahora: saber por qué no dañan a las raíces. Las plantas son fabricantes naturales de azúcares. Las raíces de las plantas secretan, expulsan azúcares al suelo. Creemos que el azúcar que expulsan las raíces es la moneda que le paga la planta a trichoderma para que este se asocie y forme una simbiosis. Es decir, que forme una colaboración con ella, y no la ataque. Otras dudas son si es capaz de atacar a otras especies cuando hay azúcar. Y eso aún está pendiente de contestar. Lo que sí pudimos encontrar es que ese azúcar que liberan las raíces es lo que le informa a trichoderma que no debe de ser agresivo. La planta de esta forma establece una relación de colaboración de mucho tiempo con este tipo de hongos. Le conviene que esté cerca de la raíz. Y a trichoderma le gusta estar cerca de las raíces de las plantas dado que encuentra alimento de manera gratuita.
-¿Desde qué lugar abordan sus estudios?
-Nuestros estudios los abordamos desde enfoque de la planta: cómo la planta ve al hongo, cómo hace para consentir con ese hongo, o permitir que se asocie con ella. En un primer estudio encontramos que el hongo libera un grupo de sustancias que actúa como hormonas en la planta. Tenemos un hongo que le regala a la planta una hormona de crecimiento. Si tuviera que resumir el trabajo que hemos hecho en estos últimos 15 años, diría que nuestro aporte es decir que los trichodermas son bioestimulantes: ayudan a la planta a funcionar.
-¿Y cómo lo hacen?
-A través de una comunicación química, un reconocimiento mutuo. Ellos fabrican sustancias (moléculas) que ayudan en la comunicación con la planta, y eso de alguna forma fortalece o hace estrecha la relación simbiótica que existe entre estos hongos y las plantas. Una vez que se ha establecido la relación -del hongo cerca de la raíz- la planta se comporta de manera diferente. Ahora ya tiene un aliado que le ayuda a combatir a sus patógenos o que la defiende de cambios en el ambiente: sequía o salinidad. Estas interacciones confieren mucha protección en esos escenarios.

-¿Qué beneficios destaca de este género?
– Es lo mismo que el yogurt: tiene muchas funciones benéficas para el humano. Uno, promueve el desarrollo de la raíz: hace que se formen raíces más robustas; es un enraizador natural. Dos, es un solubilizador de nutrientes (que fue un trabajo que publicamos hace dos años); principalmente fosfato (fósforo), que es un nutriente fundamental para las plantas. Trichoderma ayuda para que solubilice fosfato. ¿Cómo lo hace? Acidifica: hace que el suelo sea más ácido y eso suelta al fosfato (aporte robustez a las plantas). Tres, promueve el crecimiento: produce hormonas, auxinas (hormona vegetal), metabolitos, sustancias que activan el crecimiento en la planta. Se favorece la producción de biomasa, de crecimiento en tamaño, en vigor de los cultivos. Cuatro, las protege del estrés ambiental, ayuda a la planta para que se adapte mejor al cambio de temperatura, déficit de agua. Cinco, vacuna a las plantas. Hace que ellas –cuando está en simbiosis con la raíz- tenga mejor resistencia a patógenos, virus, bacterias. Y por último, su propiedad de biocontrol: aleja a los patógenos de la raíz.
-¿Cómo se adaptan a los distintos ambientes?
-Los trichodermas son cosmopolita. Uno de los retos es responder preguntas como estas. Habría que aislarlos a cada uno y ver cómo se comportan en interacciones bajo diferentes ambientes: sequía, salinidad, o suelos muy fertilizados.
-¿Hay algunos que sean más interesantes?
-Diría que más estudiados. Todos son interesantes. Los micorrícicos se han estudiado durante décadas. La diferencia es que los trichodermas son micoparásitos. Pero en el resto se parece mucho a los hongos que forman micorrizas. Una acotación que haría es que creo que no son los únicos: deben haber más especies de hongos con propiedades de bioestimulación. Dentro de los más estudiados se encuentran T. virens, T. atro atro-viride, y T. harzianum. Se hace difícil estudiar un banco amplio de trichodermas en detalle. Usualmente se toman una o dos para realizar investigaciones.

-En su caso, uds. trabajan como T. virens, y T. atro-viride. ¿Qué conclusiones sacan de ambos géneros?
-No son idénticos. Virens es un hongo más café, más oscuro. Y el otro tiene anillos de coloraciones verdes. Atro-viride libera una sustancia que tiene olor a coco. Esa molécula es de comunicación. Virens produce auxinas, que es otra forma de comunicarse con la planta. Todo tipo de interacción no da una información nueva. Es una monografía especial de ese hongo con la planta. No son idénticas las relaciones, son dinámicas, diversas. Ambos son bioestimulantes. Pero las características de los trichodermas no se han demostrado para cada especie. Hasta ahora no hay un trabajo que lo demuestre. Esas conclusiones vienen con una propiedad del género, no de cada especie en específico.
-También estudian a bacterias. ¿Qué avances tienen de ellas como bioestimulantes?
– Cultivamos a 5000 especies de bacterias, y hemos hecho interacciones con todas ellas. Y de ello, observamos diez tipos de interacciones benéficas de tipo trichodermas. Sin embargo, otras 4900 no hacen bioestimulación. Y una posible respuesta tiene que ver con ciertas condiciones que se da la interacción. Dentro del género de bacterias pseudomonas, una o dos son bioestimulantes, el resto no. Estamos en la frontera del conocimiento. Hay que profundizar para llegar a ser más específicos. Porque hay algunas que son patogénicas, y otras son promotor del crecimiento. Cada interacción es diferente. Y esa es la maravilla de la naturaleza.

-¿Qué camino abre para la ciencia estas investigaciones?
-Las plantas son la fuente de alimento del mundo. Los seres humanos dependemos de ellas y los animales también: son la base de las cadenas alimenticias. Entender la relación de las plantas con hongos que son benéficos, bioestimulantes, nos abre un camino para aplicarlo a un problema real, que es la alimentación mundial. Se abren caminos de entender cómo interaccionan los seres vivos.
-¿Es una práctica mucho más sustentable?
-Por supuesto. Si uno aplica fertilizantes u otros productos, estamos apagando todas sus funciones que tienen que ver con la adaptación. Estos hongos, al igual que otras bacterias, lo que hacen es dinamizar a la planta. Un bioestimulante es aquel factor biótico químico, ambiental, que hace que la planta se active: dinamice su metabolismo, dinamice sus funciones biológicas que usualmente se apagan con el manejo agropecuario. Eso nos lleva a cambiar la forma en que hacemos agricultura. Así como existen los productos con biocontrol, existe la posibilidad de poder utilizar estos microorganismos y hacer un producto efectivo. Eso es lo que busca la biotecnología. Hoy hay mucha gente que utiliza los trichoderma por un principio de sustentabilidad, que es la forma que se está manejando la agricultura.
CONGRESO ABORDARÁ LAS PRINCIPALES NOVEDADES SOBRE EL USO DE BIOSESTIMULANTES
Redagrícola organizará el Congreso Bioestimulantes: Un nuevo paradigma para la intensificación sustentable de la producción agrícola. El evento se realizará de forma virtual, entre el 9 al 11 de junio del 2021. El evento estará enfocado en discutir las principales novedades tecnológicas y comerciales sobre el uso de bioestimulantes en agricultura.
El objetivo es ser un punto de encuentro entre la industria latinoamericana de bioestimulantes y delegados de todo el mundo.
Las personas inscritas al congreso virtual podrán acceder a la plataforma antes, durante y hasta 30 días después de terminado el evento las 24 horas del día, desde una computadora o una aplicación móvil.
Asimismo, es importante resaltar que el evento será traducido de forma simultánea al inglés y portugués.
Los participantes también tendrán la oportunidad de participar de una experiencia virtual única, con charlas magistrales, mesas redondas, reuniones 1 a 1, así como acceso a talleres, charlas de empresas y a los perfiles virtuales de las compañías, donde las firmas podrán mostrar sus productos y dialogar en tiempo real con los asistentes.
TEMARIO
- Avances científicos en el uso agrícola de:
– Extractos de algas.
– Sustancias húmicas.
– Hidrolizados de proteínas.
– Silicio.
– Bacterias promotoras del crecimiento de los cultivos.
– Micorrizas.
- Novedades en el uso de bioestimulantes para aumentar la eficiencia del uso de los nutrientes, tolerancia de las plantas al estrés abiótico, mejoramiento de la calidad de los cultivos y aumento en los rendimientos.
- Novedades regulatorias.
- Oportunidades comerciales en los mercados Latinoamericanos.
- Nuevos productos y tecnologías en bioestimulantes.
Más informaciones: